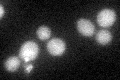
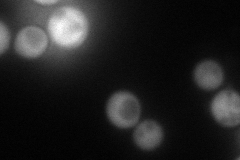
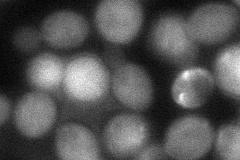

View description
Pantothenate kinase (ATP:D-pantothenate 4'-phosphotransferase, EC 2.7.1.33); catalyzes the first committed step in the universal biosynthetic pathway for synthesis of coenzyme A (CoA)
Localization:
Intensity:
Fold change:
Significance:
-
C’ GFP library in SD
cytosol32.54 -
N' NOP1pr-GFP in SD
cytosol149.528 -
N' TEF2pr-mCherry in SD

cytosol188.189 -
N' NATIVEpr-GFP in SD

missing0 -
N' TEF2pr-VC and Cyto-VN in SD
cytosol59.6689 -
C’ GFP library in SD+DTT

cytosol30.430.93No -
C’ GFP library in SD+H2O2

cytosol37.281.14No -
C’ GFP library in Starvation Media

cytosol51.241.57Yes -
C’ GFP library on the background of Pup2-DaMP

cytosol -
C’ GFP library on the background of CCT mutant

cytosol34.07691.04714No
